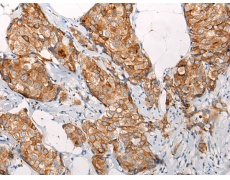
一抗

中文名稱: 兔抗EMC7多克隆抗體
|
Background: |
EMC7, also known as C15orf24, which encoding more than 700 genes, chromosome 15 is made up of approximately 106 million base pairs and is about 3% of the human genome. Angelman and Prader-Willi syndromes are associated with loss of function or deletion of genes in the 15q11-q13 region. In the case of Angelman syndrome, this loss is due to inactivity of the maternal 15q11-q13 encoded UBE3A gene in the brain by either chromosomal deletion or mutation. In cases of Prader-Willi syndrome, there is a partial or complete deletion of this region from the paternal copy of chromosome 15. Tay-Sachs disease is a lethal disorder associated with mutations of the HEXA gene, which is encoded by chromosome 15. Marfan syndrome is associated with chromosome 15 through the FBN1 gene. The C15orf24 gene product has been provisionally designated C15orf24 pending further characterization. |
|
Applications: |
ELISA, WB, IHC |
|
Name of antibody: |
EMC7 |
|
Immunogen: |
Synthetic peptide of human EMC7 |
|
Full name: |
ER membrane protein complex subunit 7 |
|
Synonyms: |
HT022; C11orf3; C15orf24; ORF1-FL1 |
|
SwissProt: |
Q9NPA0 |
|
ELISA Recommended dilution: |
5000-10000 |
|
IHC positive control: |
Human tonsil |
|
IHC Recommend dilution: |
30-150 |
|
WB Predicted band size: |
26 kDa |
|
WB Positive control: |
Human testis tissue and A549 cell lysates |
|
WB Recommended dilution: |
500-2000 |



 購物車
購物車 幫助
幫助
 021-54845833/15800441009
021-54845833/15800441009